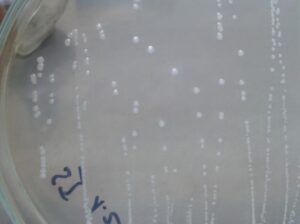
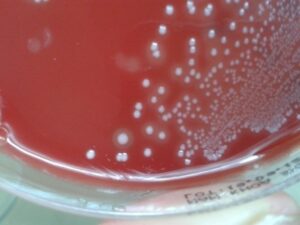
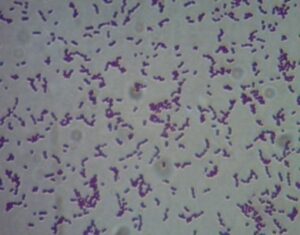

Lại Thị Lan Hương
Bộ môn GPTC
TÓM TẮT
Kết quả phân lập và xác định tính kháng nguyên, độc lực của các chủng vi khuẩn Streptococcus agalactiae gây bệnh ở cá rô phi tại 7 tỉnh Hà Nội, Hải Dương, Quảng Ninh, Đồng Tháp, Tiền Giang,Vĩnh Long, An Giang cho thấy tỷ lệ mẫu bệnh phân lập được vi khuẩn Streptococcus agalactiae là 96%. Các chủng S. Agalactiae phân lập được thuộc các chủng NS5; NS13; LX7; LX8; LX9; LX10; ĐN8; ĐN9; ĐN10; ĐN12; ĐN17;O2;TP3;TP4 có tính kháng nguyên. Độc lực của các chủng vi khuẩn S.agalactiae TP4; O2; ĐN12; LX8 và NS5 có tính độc lực mạnh.
Từ khóa: cá rô phi, vi khuẩn Streptococcus agalactiae, kháng nguyên, độc lực
SUMMARY
Isolation, antigen determination and toxicity experiments of Streptococcus agalactiae strains caused disease in Tilapia at 7 provinces of Vietnam
The result of isolation, antigen determination and toxicity experiments of Streptococcus agalactiae strains caused the disease in Tilapia at Ha Noi, Hai Duong, Quang Ninh, Dong Thap, Tien Giang, Vinh Long, An Giang showed that 96% of samples were infected with Streptococcus agalactiae. The isolated Streptococcus strains had antigent which belonged to NS5; NS13; LX7; LX8; LX9; LX10; ĐN8; ĐN9; ĐN10; ĐN12; ĐN17;O2;TP3;TP4. The virulence of Streptococcus agalactiae strains belonging to serotype TP4; O2; ĐN12; LX8 and NS5 was very strong.
Keywords: Tilapia, S. agalactiae, antigent, virulence
- ĐẶT VẤN ĐỀ
Trong những năm vừa qua, ngành thủy sản có tốc độ phát triển nhanh nhất trong các lĩnh vực sản xuất thực phẩm cho con người (Khan et al., 2011). Tại Việt Nam, nuôi trồng thủy sản đã và đang đóng vai trò quan trọng đối với nền kinh tế quốc gia với tổng sản lượng thủy sản đạt 7,28 triệu tấn năm 2017, trong đó khoảng 3,9 triệu tấn là đóng góp từ hoạt động nuôi trồng thủy sản và thủy sản xuất khẩu mang lại kim ngạch xuất khẩu đạt hơn 8,3 tỷ USD (VASEP, 2018). Tuy nhiên, việc chuyển đổi cơ cấu nuôi trồng sang nuôi thâm canh đã tạo ra nhiều hệ lụy đến môi trường và đặc biệt là gây ra nhiều loại dịch bệnh nguy hiểm, gây tổn thất kinh tế cho ngành nuôi trồng thủy sản trên toàn thế giới. Hiện nay các khu nuôi thủy hải sản nói chung, vùng nuôi cá rô phi nói riêng việc sử dụng kháng sinh trong phòng trị bệnh tràn lan, không đúng cách gây ra hiện tượng kháng kháng sinh của vi khuẩn gây bệnh trên động vật thủy sản, dẫn đến hiệu quả điều trị bệnh không có hoặc rất thấp (Sarter et al., 2007). Trong số các vi khuẩn gây bệnh trong nuôi trồng thủy sản, Streptococcus spp. là tác nhân gây bệnh ngủy hiểm vì chúng có phổ ký chủ khá rộng từ các tầm, cá hồi đến nhóm cá biển và đặc biệt là các loài các thuộc họ cá rô như cá rô phi (Toranzo và cs, 2005). Vi khuẩn S.agalactia gây bệnh trên cá rô phi có tần suất xuất hiện từ 95-100% ở các tháng có nhiệt độ cao với tỷ lệ gây chết cộng dồn lên đến 42-100% đàn cá nuôi, làm thiệt hại nghiêm trọng cho nghề nuôi cá rô phi nuôi thương phẩm tại Việt Nam, do việc dùng kháng sinh không đúng cách, vi khuẩn bị kháng kháng sinh nên điều trị bệnh bằng kháng sinh không hiệu quả (Phạm Hồng Quân et al.,2013).
Để có cơ sở cho việc nghiên cứu và chế tạo vắc xin phòng bệnh Streptococcosis trên cá rô phi, chúng tôi tiến hành phân lập xác định và kiểm tra độc lực của chủng vi khuẩn gây bệnh trên cá rô phi.
- NGUYÊN VẬT LIỆU, NỘI DUNG VÀ PHƯƠNG PHÁP NGHIÊN CỨU
2.1. Vật liệu nghiên cứu
– Mẫu bệnh phẩm là gan, thận, lách từ mẫu cá rô phi bị bệnh với các dấu hiệu bệnh lý như bơi lờ đờ mất định hướng, chướng bụng, xuất huyết, lồi mắt, sưng ruột; các cơ quan nội tạng như gan, thận, lách sưng to, xuất huyết, bạc màu
– Cá rô phi dùng thí nghiệm: Cá rô phi (vằn) giống khỏe mạnh sạch bệnh có trọng lượng trung bình 10g/con, cá rô phi (diêu hồng) giống khỏe mạnh, sạch bệnh có trọng lượng trung bình 2.5g/con. Trước khi làm thí nghiệm được nuôi và cho thích nghi với môi trường 3 ngày.
– Các loại môi trường nuôi cấy: Brain heart infusion broth (BHIB, Merck), Brain heart infusion agar (BHIA, Merck), BHI có bổ sung 5% máu cừu, nước muối sinh lý 0.85%, Kit API20 Strep (BioMerieux, Pháp)
– Thuốc gây mê, bơm tiêm, đĩa lồng nuôi cấy và các trang thiết bị phòng thí nghiệm khác.
2.2. Địa điểm nghiên cứu
– PhòngThủy sản – Trung tâm Nghiên cứu và Sản xuất sinh phẩm – Công ty cổ phần Dược và Vật tư thú y (Hanvet).
– Trung tâm Thú y vùng 6, một số phòng thí nghiệm khác.
– Trung tâm giống nông nghiệp Hậu Giang
– Các vùng nuôi cá rô phi tại các tỉnh Hà Nội, Hải Dương, Quảng Ninh, Đồng Tháp, Tiền Giang, Vĩnh Long, An Giang
– Thu mẫu cá bệnh từ các địa phương và phân lập, định danh vi khuẩn Streptococcus spp.
– Lựa chọn chủng vi khuẩn Streptococcus spp có tính kháng nguyên.
– Lựa chọn chủng vi khuẩn Streptococcus spp có độc lực cao.
2.3.1. Thu mẫu, phân lập và định danh vi khuẩn
Thu mẫu cá rô phi vằn và rô phi đỏ bị bệnh tại các tỉnh Hà Nội, Hải Dương, Hải Phòng, Quảng Ninh, Đồng Nai, Tiền Giang, Vĩnh Long, An Giang, Đồng Tháp. Mẫu cá bệnh đang còn sống hoặc mới chết. Cơ quan sử dụng để nuôi cấy phân lập vi khuẩn gồm: Gan, thận, lách, não và mắt vì đây là những cơ quan đích của vi khuẩn Streptococcus spp.
2.3.1.2. Phân lập và định danh vi khuẩn Streptococcus spp.
Nuôi cấy và phân lập vi khuẩn Streptococcus spp ở cá rô phi bằng phương pháp nghiên cứu vi khuẩn của Frerich G.N. (1984, 1993). Vi khuẩn được phân lập từ các cơ quan đích trên môi trường BHIA, chuyển về phòng thí nghiệm để phân lập và sàng lọc khuẩn tạp, từ đó chọn ra được các chủng vi khuẩn mang đặc điểm đặc trưng của vi khuẩn Streptococcus spp.
Dựa vào hình thái khuẩn lạc có đặc điểm tròn, đường kính nhỏ 1-2mm, hơi lồi và có màu trắng hơi đục. Khuẩn lạc được chọn, tiến hành soi tươi, nhuộm Gram và quan sát trên kính hiển vi ở vật kính 40X, kiểm tra đặc điểm dung huyết trên môi trường thạch máu cừu 5%. Thử các đặc tính sinh hóa bằng kít API 20 Strep (BioMerieux, Pháp).
2.3.2. Lựa chọn chủng vi khuẩn Streptococcus spp. có tính kháng nguyên.
Chế tạo kháng nguyên cho từng chủng vi khuẩn:
Sau 24 giờ vi khuẩn tăng sinh mạnh, sau đó bất hoạt vi khuẩn bằng formalin với liều lượng được tính bằng công thức:
VFormalin = 0,5% x Vdd
Trong đó: VFormalin : Thể tích formalin
Vdd : Thể tích dung dịch của môi trường canh BHI
Bảo quản trong điều kiện 40C khoảng 24 – 48 giờ. Sau khi bất hoạt vi khuẩn bằng formalin, vi khuẩn được thu nhận bằng cách li tâm môi trường đã nuôi tăng sinh vi khuẩn. Sau đó phần cô đặc nằm dưới đáy ống ly tâm, có màu trắng được thu lại. Thực hiện ly tâm 5000 vòng/phút trong vòng 15 phút. Phần cô đặc được rửa bằng nước muối sinh lý 3 lần. Sau mỗi lần rửa ly tâm lại để rửa sạch hết formalin. Cuối cùng, sản phẩm được pha với nước muối sinh lý đạt nồng độ 109 CFU/ml. Bảo quản ở nhiệt độ 4 -100C.
Kháng nguyên của từng chủng vi khuẩn sau khi chế tạo được, tiêm miễn dịch cho cá rô phi với 106 – 109 CFU/ml /con cá vào xoang bụng, mỗi chủng tiêm cho 10 con cá (lặp 3 lần). Sau 21 ngày tiến hành lấy máu và xác định hiệu giá kháng thể của huyết thanh.
Mẫu máu sau khi lấy để ở nhiệt độ phòng 3 giờ rồi ly tâm 2500rpm/5 phút để thu huyết thanh. Tiến hành phản ứng ngưng kết trên phiến kính giữa huyết thanh với vi khuẩn sống, vi khuẩn bất hoạt và nước muối sinh lý làm đối chứng. Nếu phản ứng có nhiều ngưng kết màu trắng đục, nhỏ li ti chứng tỏ là có kháng thể kháng vi khuẩn Streptococcus spp.
Dùng các chủng có kháng nguyên đã lựa chọn để gây nhiễm cho cá với LC70 (Lethal Concentration 70). Dựa vào LC70 gây chết cá để đánh giá độc lực của mỗi chủng vi khuẩn.
– Nuôi cấy tăng sinh các dòng vi khuẩn đã lựa chọn trên môi trường BHI ở 30oC trong vòng 18 giờ (Hernandez và cs., 2009)
– Định lượng vi khuẩn bằng phương pháp đếm khuẩn lạc. Gây nhiễm vi khuẩn ở các nồng độ vi khuẩn khác nhau, đối chứng bằng nước muối sinh lý. Mỗi nồng độ vi khuẩn được tiêm trên 30 con cá có trọng lượng 20g ± 5 với liều 0,2 ml/con cá ( thí nghiệm được lặp lại 3 lần).
– Cảm nhiễm bệnh nhân tạo bằng phương pháp tiêm xoang bụng sau khi cá đã được gây mê.
– Theo dõi thí nghiệm, ghi chép số lượng cá chết và kết thúc thí nghiệm sau khi cá ngừng chết 3 ngày liên tục.
– Phân lập vi khuẩn từ mẫu cá bệnh sau khi cảm nhiễm bệnh trên môi trường BHIA, kiểm tra hình thái vi khuẩn, thử phản ứng sinh hóa và test API20 Strep để khẳng định cá bị bệnh do vi khuẩn cảm nhiễm gây ra.
3.1 . Kết quả thu mẫu, phân lập và định danh vi khuẩn
3.1.1. Kết quả thu mẫu cá bệnh
Chúng tôi tiến hành phân lập vi khuẩn Streptococcus agalactiae từ 256 mẫu cá bệnh có trọng lượng từ 2g đến 450g tại các tỉnh thành Hà Nội, Hải Dương, Quảng Ninh, Đồng Tháp, Tiền Giang, Vĩnh Long, An Giang. Hầu hết các mẫu cá bệnh thu được đều có triệu chứng và bệnh tích điển hình: bơi lờ đờ, mất phương hướng; mắt lồi và đục; xuất huyết ở nắp mang, thân, gốc vây ngực và vây bụng; mang tái nhạt, bụng trướng to, xoang bụng có chứa dịch màu vàng, nội tạng bị xuất huyết, mềm nhũn. Kết quả được trình bày ở Bảng 1.
Bảng 1. Số mẫu cá bệnh thu được tại các địa phương
| Số TT | Địa điểm | Số hộ
thu mẫu |
Số lượng cá (con) | Trọng lượng(g) |
| 1 | Hà Nội | 6 | 23 | 15-280 |
| 2 | Hải Dương | 7 | 30 | 10-250 |
| 3 | Quảng Ninh | 6 | 24 | 12-320 |
| 4 | Đồng Tháp | 16 | 56 | 2-300 |
| 5 | Tiền Giang | 11 | 36 | 5-450 |
| 6 | Vĩnh Long | 9 | 35 | 5-250 |
| 7 | AnGiang | 15 | 52 | 2-430 |
| Tổng cộng | 70 | 256 | ||
3.1.2. Phân lập và định danh vi khuẩn
Trước khi tiến hành phân lập, giám định vi khuẩn gây bệnh, những mẫu cá bị bệnh ngoài da do kí sinh trùng hoặc nấm được kiểm tra để loại bỏ.
Hình 1a. Hình thái khuẩn lạc |
Hình 1b. Hình thái khuẩn lạc Streptococcus spp. trên môi trường thạch máu. |
|
Hình 1c. Hình dạng nhuộm Gram của vi khuẩn Streptococcus spp |
|
Bảng 2. Kết quả phân lập vi khuẩn từ mẫu cá bệnh
|
Tỉnh
|
Số mẫu | Aeromonas sp. | Flavobacterium sp. | Streptococcus spp. | |||
| Mẫu
(+) |
Tỉ lệ
(%) |
Mẫu
(+) |
Tỉ lệ
(%) |
Mẫu
(+) |
Tỉ lệ
(%) |
||
| Hà Nội | 23 | 8 | 34.78 | 1 | 4.34 | 22 | 95.65 |
| Hải Dương | 30 | 13 | 43.33 | 2 | 6.67 | 29 | 96.70 |
| Quảng Ninh | 24 | 5 | 20.83 | 1 | 4.17 | 23 | 95,83 |
| Đồng Tháp | 56 | 24 | 42.85 | 8 | 14.28 | 55 | 98.21 |
| Tiền Giang | 36 | 14 | 38.88 | 4 | 11.11 | 35 | 97.20 |
| Vĩnh Long | 35 | 8 | 22.85 | 3 | 8.57 | 34 | 97.14 |
| An Giang | 52 | 14 | 26.92 | 6 | 11.53 | 51 | 98.07 |
| Tổng | 256 | 86 | 33.59 | 25 | 9.76 | 249 | 97.26 |
Ghi chú:(+): số mẫu nhiễm
Qua bảng 2, trong tổng số 256 mẫu cá rô phi bị bệnh xuất hiện 3 loại vi khuẩn là: Aeromonas sp., Flavobacterium sp.và Streptococcus spp. Trong đó, số mẫu có vi khuẩn Streptococcus spp. cao nhất 249/256 mẫu chiếm tỉ lệ 97,26%; số mẫu có vi khuẩn Aeromonas sp. là 86/256 chiếm tỉ lệ 33.59%; số mẫu xuấthiện Flavobacterium sp. là 9.76%. Kết quả nghiên của chúng tôi tương đồng với các công bố trước đây của Phạm Hồng Quân và cs, (2013), có 74/86 mẫu dương tính với vi khuẩn Streptococcus spp. chiếm tỉ lệ 86,05% (Nguyễn Viết Khuê và cs. ,2009); tỉ lệ dương tính với vi khuẩn này là 90% (Liu và cs, 2012).
Sau khi định danh bằng kít API 20Strep, chúng tôi xác định được cả 249 mẫu vi khuẩn Streptoccocus spp. phân lập được ở trên đều là S.agalactiae. Các mẫu vi khuẩn này được giữ trong tủ nhiệt độ -800C để các đặc tính của vi khuẩn ít bị biến đổi.
3.2. Kết quả lựa chọn chủng kháng nguyên
Với mục đích lựa chọn được chủng vi khuẩn đưa vào nghiên cứu sản xuất vắc xin ở quy mô công nghiệp ứng dụng thực tiễn nên cần thiết phải lựa chọn những chủng vi khuẩn có tính kháng nguyên ổn định, có khả năng kích thích cơ thể cá sinh đáp ứng miễn dịch cao, có khả năng bảo hộ rộng.
Đánh giá tính kháng nguyên của các chủng vi khuẩn dựa trên phản ứng ngưng kết với nguyên tắc của sự liên kết giữa kháng nguyên và kháng thể có thể nhìn thấy được ở dạng kết khối. Kết quả thể hiện ở bảng 2.
+ Các chủng vi khuẩn có phản ứng dương tính: kháng nguyên bị ngưng kết thành từng đám lấm tấm trên phiến kính, mắt thường có thểnhìn thấy được thì lựa chọn.
+ Các chủng vi khuẩn có phản ứng âm tính: Không có hiện tượng ngưng kết thì loại.

Hình 2. Kết quả phản ứng ngưng kết nhanh trên phiến kính
A: Âm tính; B: Dương tính với vi khuẩn sống; C: Dương tính với vi khuẩn bất hoạt.

Hình 3. Cụm ngưng kết quan sát dưới kính hiển vi
Kết quả kiểm tra phản ứng ngưng kết, chúng tôi thu được 14/246 mẫu vi khuẩn có tính kháng nguyên là các chúng S. agalactiaecó các ký hiệu là các chủng có ký hiệu NS5; NS13; LX7; LX8; LX9; LX10; ĐN8; ĐN9; ĐN10; ĐN12; ĐN17;O2;TP3;TP4
3.3. Kết quả lựa chọn chủng độc lực
Từ 14 chủng vi khuẩn có tính kháng nguyên, để kiểm tra độc lực của các chủng vi khuẩn này chúng tôi tiến hành kiểm tra độc lực; trên cá rô phi có trọng lượng 20g ± 5 ở nồng độ từ 106 đến 1010 CFU/ml. Mỗi nồng độ tiêm trên 30 cá với liều 0,2 ml/con cá (các thí nghiệm được lặp lại 3 lần). Sau 24 giờ gây nhiễm hầu hết các lô cá thử độc lực với liều 0,2 x 108 – 1010 cfu/ml/con cá có biểu hiện bệnh với dấu hiệu và bệnh lý điển hình là xuất huyết, lồi mắt, cá chết sau 36 giờ gây nhiễm, riêng O2 cá thử độc lực ở liều 106 đã có các biểu hiện trên và chết sau 36 giờ gây nhiễm.
 |
 |
|
Hình 3. Dấu hiệu bệnh lý của cá sau khi công bằngvi khuẩn S.agalctia độc lực . |
|
Bảng 3. Kết quả thử độc lực của các chủng vi khuẩn S.agalactiae
| Số TT | Mã VK | Mật độ VK tiêm (cfu/ml) | Số cá chết/cá tiêm (con) | Tỷ lệ chết (%) |
| 1. | NS5 | 1010 | 0/30 | 100,00 |
| 109 | 2/30 | 93,33 | ||
| 108 | 28/30 | 16,7 | ||
| 2. | NS13 | 1010 | 6/30 | 60,00 |
| 109 | 9/30 | 30,00 | ||
| 108 | 30/30 | 0,00 | ||
| 3. | LX7 | 1010 | 9/30 | 70,00 |
| 109 | 15/30 | 50,00 | ||
| 108 | 0/30 | 0,00 | ||
| 4. | LX8 | 1010 | 0/30 | 100,00 |
| 109 | 0/30 | 100,00 | ||
| 108 | 21/30 | 30,00 | ||
| 5. | LX9 | 1010 | 13/30 | 43,33 |
| 109 | 9/30 | 30,00 | ||
| 108 | 0/30 | 0,00 | ||
| 6. | LX10 | 1010 | 15/30 | 50,00 |
| 109 | 10/30 | 33,33 | ||
| 108 | 0/30 | 0,00 | ||
| 7. | ĐN8 | 1010 | 0/30 | 100,00 |
| 109 | 7/30 | 76,66 | ||
| 108 | 0/30 | 0,00 | ||
| 8. | ĐN9 | 1010 | 6/30 | 80,00 |
| 109 | 12/30 | 60,00 | ||
| 108 | 0/30 | 0,00 | ||
| 9. | ĐN10 | 1010 | 9/30 | 70,00 |
| 109 | 18/30 | 40,00 | ||
| 108 | 0/30 | 0,00 | ||
| 10. | ĐN12 | 1010 | 0/30 | 100,00 |
| 109 | 1/30 | 96,66 | ||
| 108 | 6/30 | 20,00 | ||
| 11. | ĐN17 | 1010 | 6/30 | 80,00 |
| 109 | 8/30 | 26,66 | ||
| 108 | 30/30 | 0,00 | ||
| 12. | O2 | 1010 | 0/30 | 100,00 |
| 109 | 0/30 | 100,00 | ||
| 108 | 3/30 | 96,6 | ||
| 107 | 7/30 | 87,70 | ||
| 106 | 21/30 | 30,00 | ||
| 13. | TP3 | 1010 | 21/30 | 70,00 |
| 109 | 15/30 | 50,00 | ||
| 108 | 0/30 | 0,00 | ||
| 14. | TP4 | 1010 | 0/30 | 100,00 |
| 109 | 7/30 | 76,66 | ||
| 108 | 0/30 | 0,00 |
Kết quả ở bảng 3 cho thấy, ngoài chủng O2 có cá chết 30% ở nồng độ vi khuẩn 106CFU/ml còn các chủng khác không có biểu hiện bệnh hoặc chết khi công cường độc ở nồng độ vi khuẩn 106- 107 CFU /ml. Ở nồng độ vi khuẩn 108CFU/ml có một số vi khuẩn gây chết cá nhưng tỷ lệ không cao. Ở nồng độ vi khuẩn 109 CFU/ml, có 5 chủng gây chết với tỷ lệ >70% cá thí nghiệm là các chủng TP4; O2; ĐN12; LX8 và NS5, các lô đối chứng không có cá chết.
So sánh với báo cáo của Bromage (1999) thì độc lực của các chủng thí nghiệm thấp hơn độc lực của chủng vi khuẩn S. iniae phân lập từ cá chẽm và cá rô phi đỏ nuôi ở Úc (LC50 = 3,2 x 104CFU) (Vacxin Adjuvants , 2010) và ở Thái Lan (LC50 = 1,08 x 104CFU) (Suanyuk, 2010).
Những cá có dấu hiệu bệnh hoặc chết sau khi cảm nhiễm tại các lô thí nghiệm đều được giải phẫu để kiểm tra, quan sát sự biến đổi bệnh lý của các cơ quan nội tạng. Sau đó tiến hành tái phân lập vi khuẩn từ gan, thận, mắt và não cá trên môi trường BHIA ở nhiệt độ 30oC, trong 24 giờ. Thấy khuẩn lạc ở các đĩa môi trường BHIA có màu sắc và hình thái giống với khuẩn lạc của vi khuẩn Streptococcus spp. phân lập từ mẫu cá rô phi lúc thu mẫu.
- KẾT LUẬN
– 256 mẫu cá bệnh trên 7 tỉnh Hà Nội, Hải Dương, Quảng Ninh, Đồng Tháp, Tiền Giang, Vĩnh Long, An Giang, phân lập được 249 chủng vi khuẩn S.agalactiae (chiếm 96…%).
– 14 chủng S.agalactia có tính kháng nguyên. Từ 14 chủng có tính kháng nguyên chọn được 5 chủng có độc lực mạnh.
TÀI LIỆU THAM KHẢO
- Bromage E. S., Thomas A. and Owens L. (1999) Streptococcus iniae, a bacterial infection in barramundi Lates calcarifer. Diseases of Aquatic Organisms, 36: 177-181
- Frerichs, G.N & Millar (1993). Manual for the isolation and identification of fish bacterial pathogens. Pisces Press. Stirling, pp. 58
- Hernandez, E., J. Figueroa and C. Iregui, (2009). Streptococcosis on a red tilapia, Oreochromis sp., farm: A case study. J. Fish Dis., 32: 247-252.
- Khan, M., Khan, S.,Miyan, K. (2011) Aquaculture as a food production system: A review. Biol Med. 3, 291-302.
- Liu Liping, Zhang Zongfeng, Zhang Wembo, Francis Murray, David Little. 2012 Tilapia aquaculture in China: Low market prices, other issues challenge as sector seeks sustainability. Global Aquaculture Advocate, Vo 15. Issue 2, March/ April 2012, pp.20-21
- Nguyễn Viết Khuê, Trương Thị Mỹ Hạnh, Đồng Thanh Hà, Nguyễn Thị Hà, Phạm Thành Đô, Bùi Ngọc Thanh, Nguyễn Thị Nguyện, Nguyễn Hải Xuân, Phạm Thái Giang và Nguyễn Thị Thu Hà (2009). “Xác định nguyên nhân gây chết hàng loạt cá rô phi nuôi thương phẩm tại một số tỉnh miền Bắc”, Báo cáo khoa học Viện Nghiên cứu Nuôi trồng Thủy sản 1.
- Phạm Hồng Quân, Hồ Thu Thủy, Nguyễn Hữu Vũ, Huỳnh Thị Mỹ Lệ, Lê Văn Khoa (2013) một số đặc tính sinh học của vi khuẩn Streptococcus spp, gây bệnh xuất huyết ở cá rô phi nuôi tại một số tỉnh miền Bắc. Tạp chí khoa học phát triển tập 11số 4-2013, trang 506-513.
- Sarter, S., Kha, N. H. N., Hung, L.T., Jérôme Lazard, J. & Montet, D. 2007 Antibiotic resistance in Gram-negative bacteria isolated from farmed catfish. Food Control 18: 1391-1396
- Toranzo, A.E., Magarin B., Romalde J.L (2005). A review of the main bacterial fish diseases mariculture systems. Aquaculture 246: 37-61.
- Vacxin Adjuvants: Methods and Protocols Edited by Gwyn Davies., 2010. Humana Press © Springer Science Business Media, LLC 2010. ISSN 1064-3745. pp 314
11. VASEP (2018). Tổng quan ngành thủy sản Việt Nam. http://vasep.com.vn/1192/Onecontent/tong-quan-nganh.htm

English
English